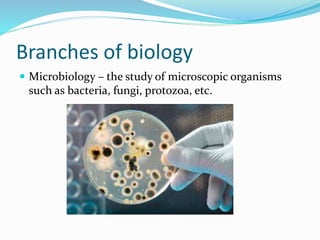
Branches of biology
 Microbiology – the study of microscopic organisms
such as bacteria, fungi, protozoa, etc.

Biology is the scientific study of living things. Key characteristics of living things include cellular organization, reproduction, metabolism, homeostasis, heredity, response to stimuli, growth and development, and adaptation through evolution. There are many branches of biology that study different aspects of life, including anatomy, physiology, botany, zoology, ecology, genetics, and molecular biology. The scientific method is used to systematically study and understand living organisms.